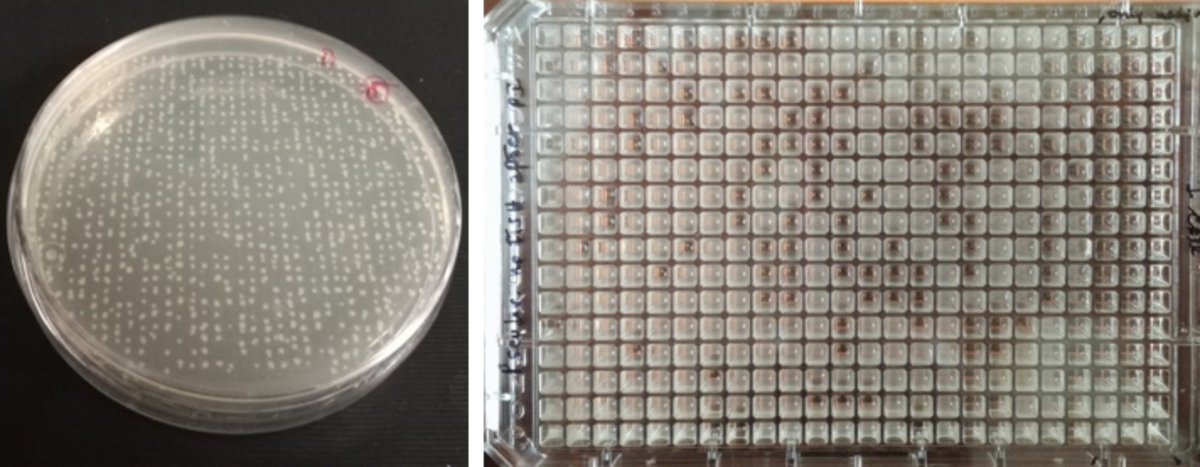

MoFlo Astrios EQ High Speed Zellsortierer
Der Astrios EQ High Speed Zellsortierer von Beckman Coulter ist mit 4 Lasern (355nm, 488nm, 532nm, 640nm) ausgestattet und ermöglicht eine simultane Sortierung von bis zu 6 Populationen in eine Vielzahl unterschiedlicher Empfängergefäße (Tubes oder Platten, Agar-oder Wellplatten) mit einer validierten Sortierrate von bis zu 70,000 Ereignissen/ Sekunde (bei einer validierten Erfassungsrate von >100.000 Ereignissen/Sekunde)
Möchten Sie Zellen vereinzeln bzw. eine bestimmte Zellpopulation aus ihrer Probe anreichern? Melden Sie sich bei Kristina Bayer oder Ute Hentschel.
Wissenschaftliche Anwendungen
Direkte Sortierung von Bakterien auf Agarplatten oder in Well-Platten
Analyse und Mikroskopie von phagozyzierenden Schwammzellen
Sortierung von GFP-exprimierenden Darmzellen aus D. melanogaster
Density plot - Stammzellen aus den Därmen von Fliegen wurde anhand ihrer GFP-Markierung heraussortiert und angereichert (in Kooperation mit der AG Prof. T. Roeder/ CAU) © K. Bayer